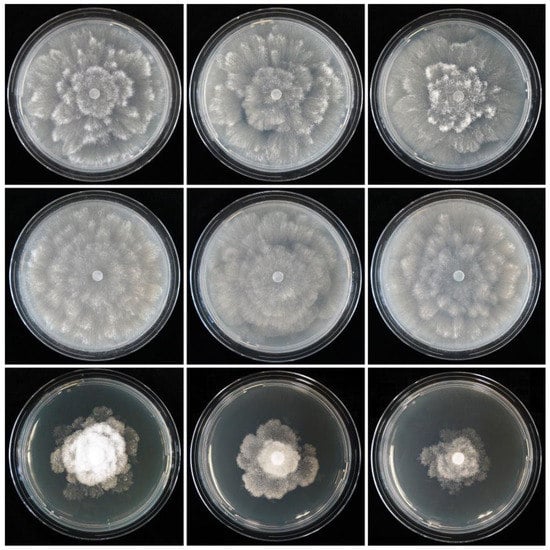

Abstract
During a survey of Phytophthora diversity in Panama, fast-growing oomycete isolates were obtained from naturally fallen leaves of an unidentified tree species in a tropical cloud forest. Phylogenetic analyses of sequences from the nuclear ITS, LSU and ßtub loci and the mitochondrial cox1 and cox2 genes revealed that they belong to a new species of a new genus, officially described here as Synchrospora gen. nov., which resided as a basal genus within the Peronosporaceae. The type species S. medusiformis has unique morphological characteristics. The sporangiophores show determinate growth, multifurcating at the end, forming a stunted, candelabra-like apex from which multiple (8 to >100) long, curved pedicels are growing simultaneously in a medusa-like way. The caducous papillate sporangia mature and are shed synchronously. The breeding system is homothallic, hence more inbreeding than outcrossing, with smooth-walled oogonia, plerotic oospores and paragynous antheridia. Optimum and maximum temperatures for growth are 22.5 and 25–27.5 °C, consistent with its natural cloud forest habitat. It is concluded that S. medusiformis as adapted to a lifestyle as a canopy-dwelling leaf pathogen in tropical cloud forests. More oomycete explorations in the canopies of tropical rainforests and cloud forests are needed to elucidate the diversity, host associations and ecological roles of oomycetes and, in particular, S. medusiformis and possibly other Synchrospora taxa in this as yet under-explored habitat.
Keywords:
oomycete; evolution; phylogeny; caducity; synchronous sporulation; adaptation; homothallic; tropical; canopy; leaf pathogen 1. Introduction
The Peronosporaceae, a sister family of the Pythiaceae, belong to the Peronosporales, Peronosporomycetes, Stramenipila and currently comprise 25 genera, i.e., Calycofera, Halophytophthora, Nothophytophthora, Phytophthora, Phytopythium and 20 genera of downy mildews (DMs) [1,2,3,4,5,6,7,8,9]. Several phylogenetic studies have demonstrated that Phytophthora is monophyletic, with all DMs residing as two separate clades within Phytophthora, rendering Phytophthora paraphyletic with respect to its DM descendants [4,6,7,8,10,11,12,13,14,15,16]. Due to the monophyly and the biological and structural cohesion of Phytophthora, its historic and social impacts and its importance in scientific communication and biosecurity protocols, Brasier et al. [16] proposed to conserve the current nomenclatural status. They also argued that paraphyletic jumps, such as the emergence of descendants with a new lifestyle (the DMs) from an ancestral and evolutionary successful, cohesive genus (Phytophthora), should be considered a normal feature of evolution. Unlike Phytophthora, the genus Pythium was, in multigene phylogenetic analyses, shown to be polyphyletic [10,12,17,18,19] and, consequently, divided into Pythium sensu stricto and four new genera, i.e., Phytopythium (syn. Ovatisporangium), Elongisporangium, Globisporangium and Pilasporangium [20,21,22,23]. Because of its phylogenetic relatedness and morphological similarity to Phytophthora, Phytopythium was assigned to the Peronosporaceae, whereas the other four genera constitute the Pythiaceae [4,6,9,22].
In 1952, Gäumann [24], based on morphological and pathogenic data, postulated an evolutionary development from the saprophytic Pythium species via hemibiotrophic or necrotrophic Phytophthora species to the obligate biotrophic downy mildews, which was confirmed later by various phylogenetic analyses. While Calycofera, Halophytophthora and Phytopythium species are mostly saprotrophs and/or necrotrophic opportunistic plant pathogens, most Phytophthora species have a hemibiotrophic or necrotrophic lifestyle as primary plant pathogens. In addition, predominantly aquatic Phytophthora species within phylogenetic clades 6, 9 and 10 have a partially saprotrophic lifestyle, and 46.7% of the 210 known culturable Phytophthora species are able to thrive as saprotrophs in waterbodies [5,9,16,25,26,27,28,29,30,31,32,33,34]. In contrast, all ca 900 DM species are highly specialised, obligate biotrophic plant pathogens [4,13,14,35]. The genera Calycofera, Halophytophthora and Phytopythium lack sporangial caducity congruent with their soilborne and/or aquatic lifestyle. In contrast, 75% of the eight described Nothophytophthora species, 26.7% of the 210 described Phytophthora species and all ca 900 DM species have caducous sporangia (or conidia), enabling an aerial or partially aerial lifestyle [4,5,6,9,13,14,16,22,31,34,35,36].
Since the 1960s, the number of devastating epidemics caused by introduced invasive Phytophthora species, including P. austrocedrae, P. cinnamomi, P. lateralis, P. plurivora, P. ramorum, P. ×alni or P. ×cambivora in both managed and natural ecosystems, has been increasing exponentially [16,26,37,38,39,40,41,42,43,44,45,46,47,48,49,50,51,52,53,54,55,56,57,58,59,60,61,62,63,64,65,66,67,68,69,70,71]. This has stimulated extensive Phytophthora surveys in previously unexplored natural ecosystems across most continents using classical baiting and isolation methods and sometimes metagenomic approaches as well. These surveys have unveiled an unprecedented diversity of described and previously unknown Phytophthora taxa in various ecological niches [6,16,30,31,41,44,45,47,72,73,74,75,76,77,78,79,80,81,82,83,84,85,86,87,88,89,90,91,92,93,94].
During a survey of Phytophthora diversity in Central America, fast-growing isolates that morphologically resemble the Phytophthora species were obtained from naturally fallen leaves in a tropical cloud forest in Panama. A preliminary phylogenetic analysis of ITS rDNA sequences suggested that they belong to a previously unknown distinct species from a potentially new Peronosporaceae genus. In this study, morphological and physiological characteristics were used in combination with DNA sequence data from three nuclear, i.e., ITS, part of the 28S large subunit (LSU) and β–tubulin, and the two mitochondrial cox1 and cox2 gene regions to characterise and officially describe the new oomycete genus as Synchrospora gen. nov. and the new taxon as S. medusiformis sp. nov.
2. Materials and Methods
2.1. Isolate Collection and Maintenance
Details of all isolates used in the phylogenetic, morphological and temperature–growth studies are given in Table 1 and Table S1. Sampling and isolation methods from naturally fallen necrotic leaves were according to [45]. For all isolates, single hyphal tip cultures were produced under the stereomicroscope from the margins of fresh cultures on V8–juice agar (V8A; 20 g agar, 3 g CaCO3, 100 mL Campbell’s V8 juice, 900 mL distilled water). Stock cultures were maintained on V8A and carrot agar (CA; 20 g agar, 3 g CaCO3, 200 g carrots, 1000 mL distilled water; [68]) at 20 °C in the dark. All isolates of the new genus Synchrospora were preserved in the culture collection maintained at the Phytophthora Research Centre, Mendel University, in Brno. The ex–type culture was deposited at the Westerdijk Fungal Biodiversity Institute, Utrecht, Netherlands (Table 1), and the novel taxonomic description and nomenclature were submitted to MycoBank (www.mycobank.org).

Table 1.
Details of Synchrospora isolates used in the morphological and growth–temperature studies.
2.2. DNA Extraction, Amplification and Sequencing
For all five Synchrospora isolates obtained in this study, 10 ex-type isolates from the genera Halophytophthora and Nothophytophthora and the neotype isolates of P. infestans and P. ×cambivora DNA were extracted from c. 15–100 mg of mycelium scraped from 1–3-wk-old V8A cultures, placed into 2 mL homogenisation tubes (Lysis Matrix A; MP Biomedicals, Irvine, USA) and disrupted using a Precellys Evolution instrument (Bertin Technologies, Montigny-le-Bretonneux, France) until the mixture was homogenous. DNA was purified using the Monarch Genomic DNA Purification Kit (New England Biolabs, Ipswich, USA) and treated with RNase A following the manufacturer’s protocol for tissue samples. DNA was eluted with 100 μL of pre-warmed elution buffer and preserved at −80 °C for long-term storage. Three nuclear gene regions, i.e., the internal transcribed spacer region (ITS1–5.8S–ITS2) of the ribosomal RNA gene (ITS), the 5′ terminal domain of the large subunit (28S-LSU) of the nuclear ribosomal RNA and β-tubulin (βtub), and the two mitochondrial genes cytochrome-c oxidase 1 (cox1) and 2 (cox2), were amplified and sequenced (Table 2). PCR amplifications were performed using a LightCycler 480 II instrument (Roche, Basel, Switzerland) or Eppendorf Mastercycler nexus GSX1 (Eppendorf, Hamburg, Germany). All primers were synthesised by Elizabeth Pharmacon spol. s.r.o. (Brno, Czech Republic). Their annealing temperatures were estimated using a Tm calculator (http://tmcalculator.neb.com/#!/main, accessed on 24 February 2023) and adjusted empirically, according to observed PCR amplification rates. Table 2 provides a comprehensive overview of the PCR conditions and primers used. Primer FM35_Oom2 was designed using a global alignment of cox2 sequences from all described species of Calycofera, Halophytophthora, Nothophytophthora, Phytophthora, Phytopythium and selected species from other oomycete genera. Each nucleotide was carefully checked to identify whether it is conserved and, if necessary, replaced by a degenerate nucleotide. PCR products were visualised by gel electrophoresis (300 V; 5 min) using 2% agarose gel stained by DNA Stain G (SERVA, Heidelberg, Germany). All amplicons were purified and sequenced in both directions by Eurofins Genomics GmbH (Cologne and Ebersberg, Germany) using the amplification primers, except for the LSU amplicons, which required two additional primers (Table 2). Electropherograms were quality checked, and forward and reverse reads were compiled using Geneious Prime® v. 2022.0.2 (Biomatters Ltd., Auckland, New Zealand). Pronounced double peaks were considered as heterozygous positions and labelled according to the IUPAC (International Union of Pure and Applied Chemistry; https://iupac.org, accessed on 24 February 2023) coding system. All sequences generated in this study were deposited in GenBank, and accession numbers are given in Table S1.
2.3. Phylogenetic Analyses
The sequences obtained in this work were complemented with sequences deposited in GenBank. Sequences of all loci used in the analyses were aligned using the MAFFT v. 7 [95] plugin within the Geneious Prime® v. 2023.0.4 software (Biomatters Ltd., Auckland, New Zealand) by the E-INS-I strategy (ITS) or the G-INS-I strategy (all other loci).
To study the phylogenetic position of the potentially new genus among other oomycete genera, a five-partition (LSU–ITS–βtub–cox1–cox2) dataset of representative species from all genera of the Peronosporaceae and Pythiaceae together with five isolates from the new species were analysed with Saprolegnia parasitica (CBS 223.65) and Aphanomyces euteiches (ATCC 201684) as outgroups (dataset: 60 isolates and 4954 characters). Maximum likelihood (ML) and Bayesian (BI) analyses were carried out.
Within the ML analysis, each gene was treated as a separate partition, and best-fitting evolutionary models were estimated with PartitionFinder 2 [96] based on the corrected Akaike Information Criterion (AICc). The analysis was done for both linked and unlinked branch lengths, and the results were the same. The largest set of models possible was tested, including models with base frequencies estimated using maximum likelihood (84 models in total; option models = allx;). All possible partitioning schemes were analysed (option search = all;).
Phylogenetic inference estimated based on the ML method was produced in RAxML-NG 1.1.0 [97]. The necessary number of bootstrap replicates was determined automatically using the MRE-based bootstrapping test [98] with the default cut-off value 0.03 (option --bs-cutoff 0.03). The analysis converged before reaching the maximum number of replicates, which was set to 10,000 (option –autoMRE{10000}). As a support metric, we used Transfer Bootstrap Expectation [99]. As a summarising tree, the 50% majority rule consensus tree was created using SumTrees 4.4.0 within the Python library DendroPy 4.4.0 [100]. Edge lengths of the summarising tree were calculated as mean lengths for the corresponding edges in the input set of trees.
For the BI analysis, a Metropolis-coupled MCMC method (MC3) implemented in the CoupledMCMC package [101] with four chains (three heated and one cold) was used. The chain length was set to 20,000,000, and every 5000th state was sampled. Target switch probability was set to the recommended value of 0.234 [102,103]. Site models for individual genes were selected automatically by model averaging implemented in the bModelTest package [104]. The uncorrelated lognormal relaxed molecular clock model [105] was used. Substitutions per site were used as the unit of branch lengths of the sampled trees. Parameter estimates were summarised with TreeAnnotator 2.6.0 (part of BEAST 2) and mapped onto the 50% majority-rule consensus tree built with SumTrees 4.4.0 [100]. The option “force-rooted“ was used, telling SumTrees to treat the tree as rooted. Edge lengths were calculated as mean lengths for the corresponding edges in the input set of trees. The posterior estimates of the parameters were summarised with Tracer 1.7.1 [106]. The quality of the parameter estimates was assessed based on visual analysis of trace plots and ESS values. Proper sampling was indicated by the minimum ESS value of 200 (standard approach). Likelihood and most of the other parameters of the final tree were higher than 200. Burn-in was set to 25%. Branches with a support value ≤ 0.5 were collapsed using TreeGraph 2 [107].
Phylogenetic trees were visualised in TreeGraph2 v. 2.15.0-887 beta [107] and/or MEGA 11 v. 11.0.11 [108] and edited in figure editor programs. The dataset and trees deriving from BI and ML analyses are available from the Dryad Digital Repository (https://datadryad.org; https://doi.org/10.5061/dryad.p2ngf1vvt).

Table 2.
PCR conditions and details of primers used for amplification and sequencing of oomycete isolates.
Table 2.
PCR conditions and details of primers used for amplification and sequencing of oomycete isolates.
| Locus | Primer Names | Primer Sequences (5′-3′) | Orientation | Annealing Temperature (°C); Extension Time (s) | Reference for Primer Sequences |
|---|---|---|---|---|---|
| βtub 1,2 | TUBUF2 TUBUR1 | CGGTAACAACTGGGCCAAGG CCTGGTACTGCTGGTACTCAG | Forward Reverse | 68; 12 | [12] |
| Btub_F1A | GCCAAGTTCTGGGARGTSAT | Forward | 66; 15 | [109] | |
| Btub_R1A | CCTGGTACTGCTGGTAYTCMGA | Reverse | |||
| cox1 | OomCoxI-Levup 1OomCoxI-Levlo 1 | TCAWCWMGATGGCTTTTTTCAAC CYTCHGGRTGWCCRAAAAACCAAA | Forward Reverse | 60; 10 | [110] |
| COXF4N 3COXR4N 3 | GTATTTCTTCTTTATTAGGTGC CGTGAACTAATGTTACATATAC | Forward Reverse | 50; 65 | [12] | |
| cox2 | FM35 1,4 OomCoxI-Levlo | CAGAACCTTGGCAATTAGG CYTCHGGRTGWCCRAAAAACCAAA | Forward Reverse | 60; 20 | [110,111] |
| FM35_Oom2 3,4 OomCoxI-Levlo | SCNKWACCTTGGCAAWTRGG CYTCHGGRTGWCCRAAAAACCAAA | Forward Reverse | 50; 80 | [this study] [110] | |
| cox1 and cox2 3,4 | FM35 COXR4N OomCoxI-Levlo 5 FM83_Oom 5 FM80_RC 5 COX2-R 5 | CAGAACCTTGGCAATTAGG CGTGAACTAATGTTACATATAC CYTCHGGRTGWCCRAAAAACCAAA CHCCNATAAARAATAACCARAARTG TTTCAACAAATCATAAAGATAT CCATGATTAATACCACAAATTTCACTAC | Forward Reverse Reverse Reverse Forward Reverse | 50; 150 | [12,31,110,111,112,113] |
| ITS 1 | ITS1 ITS4 6 ITS6 6 | TCCGTAGGTGAACCTGCGG TCCTCCGCTTATTGATATGC GAAGGTGAAGTCGTAACAAGG | Forward Reverse Forward | 63–65; 12 | [10,114] |
| LSU 1,7 | CTB6 LR3 5 LR3R 5 LR7 | GCATATCAATAAGCGGAGG CCGTGTTTCAAGACGGG GTCTTGAAACACGGACC TACTACCACCAAGATCT | Forward Reverse Forward Reverse | 53; 20 | [115,116] |
1 PCR protocol 1: 20 µL volume containing 10.4 µL H2O, 4 µL Q5 Reaction Buffer (5X), 1 µL of each primer (10 μM), 0.4 µL deoxynucleotide (dNTP) mixture (Meridian Bioscience, Memphis, USA) (2.5 mM each), 0.2 µL of Q5 High-Fidelity DNA Polymerase (2 U/μL) (New England Biolabs, Ipswich, USA), and 3 µL of gDNA. Initial denaturation for 30 s at 98 °C; 35 cycles consisting of 5 s at 98 °C, 20 s at optimised annealing temperature for each primer set, optimised length of extension at 72 °C; 2 min at 72 °C for final extension. 2 Two primer pairs were used separately: TUBUF2/TUBUR1 or Btub_F1A/Btub_R1A. 3 PCR protocol 2: 20 µL volume containing 10 µL H2O, 4 µL PrimeSTAR GXL Buffer (5X), 0.8 µL of each primer, 1.6 µL dNTP mixture, 0.4 µL PrimeSTAR GXL DNA Polymerase (1.25 U/μL) (TaKaRa Bio, Kusatsu, Shiga, Japan), and 3 µL of gDNA. Initial denaturation for 5 s at 98 °C; 35 cycles consisting of 10 s at 98 °C, 15 s at optimised annealing temperature, optimised length of extension at 68 °C; 5 min at 68 °C for final extension. 4 Three different primer pairs were used separately for COX II amplification: FM35/OomCoxI-Levlo or FM35_Oom2/OomCoxI-Levlo or FM35_Oom2/COX4RN (in this case also COX I was amplified too). 5 Primers used exclusively for sequencing. 6 Two primer combinations were used separately: ITS1/ITS4 or ITS6/ITS4. 7 Double concentration of Q5 polymerase.
2.4. Morphology of Asexual and Sexual Structures
Formation of sporangia was induced by submersing two 12–15 mm square discs cut from the growing edge of a 2–4-d-old V8A colony in a 90-mm-diameter Petri dish in non–sterile soil extract (50 g of oak forest soil in 1 000 mL of distilled water, filtered after 24 h) [39]. The Petri dishes were incubated at 20 ºC, and natural daylight and the soil extract changed after ca 6 h [74]. Shape, type of apex, caducity, pedicels and special features of sporangia were recorded after 24–48 h. For each isolate, 50 sporangia were measured at ×400 using a compound microscope (Zeiss Imager.Z2), a digital camera (Zeiss Axiocam ICc3) and biometric software (Zeiss ZEN).
The formation of gametangia (oogonia and antheridia) and their characteristic features were examined after 21–30 d growth at 20 °C in the dark on V8A. For each isolate, 50 oogonia, oospores and antheridia chosen at random were measured under a compound microscope at ×400. The oospore wall index was calculated according to [117].
2.5. Colony Morphology, Growth Rates and Cardinal Temperatures
Colony growth patterns of all five isolates of S. medusiformis were described from 7-d-old cultures grown at 20 °C in the dark in 90-mm plates on CA, V8A and potato–dextrose agar (PDA; HiMedia, Mumbai, India) according to patterns observed previously [9,31,61].
For temperature–growth relationships, all five isolates of S. medusiformis were sub–cultured onto 90 mm V8A plates and incubated for 24 h at 20 °C to stimulate onset of growth [118]. Then, three replicate plates per isolate were transferred to 5, 10, 15, 20, 22.5, 25, 27.5, 30, 32.5 and 35 °C. Radial growth was recorded after 4–10 days, before colonies reached the margin of the Petri dishes, along two lines intersecting the centre of the inoculum at right angles, and the mean growth rates (mm/d) were calculated. To determine the lethal temperature, plates showing no growth at 27.5, 30, 32.5 or 35 °C were returned to 20 °C.
3. Results
3.1. Phylogeny
Both the BI and the ML analyses of the 5–partition (LSU–ITS–βtub–cox1–cox2) dataset (4954 characters) produced phylogenetic trees with full support for both the deeper and end nodes and almost identical topology. The Bayesian tree is presented here with both Bayesian Posterior Probability values and Maximum Likelihood bootstrap values included (Figure 1, Dryad Dataset, https://doi.org/10.5061/dryad.p2ngf1vvt). The five known Peronosporaceae genera, Calycofera, Phytopythium, Halophytophthora, Nothophytophthora and Phytophthora, were well differentiated with full support, as were the Pythiaceae genera Elongisporangium, Globisporangium, Pilasporangium and Pythium (Figure 1). The mostly terrestrial soil-, air- and waterborne genera Phytophthora and Nothophytophthora constituted sister genera with the predominantly marine genus Halophytophthora residing in a basal position to them. “Halophytophthora” exoprolifera belonged to an undescribed distinct genus basal to the Halophytophthora–Nothophytophthora–Phytophthora cluster, while the cluster comprising the sister genera Calycofera and Phytopythium resided in a basal position to the other known Peronosporaceae genera, confirming recently published phylogenies [6,9,36]. The five isolates of the new species Synchrospora medusiformis formed a fully supported distinct clade that resided in a basal position to the cluster comprising the described Peronosporaceae genera, suggesting Synchrospora as the basal genus of the Peronosporaceae.

Figure 1.
Fifty percent majority rule consensus phylogram derived from Bayesian phylogenetic analysis of a concatenated five–loci (LSU, ITS, βtub, cox1, cox2) dataset of Synchrospora gen. nov. and representative species from other genera of the Peronosporaceae and Pythiaceae. Bayesian posterior probabilities and maximum likelihood bootstrap values (in %) are indicated but not shown below 0.9 and 70%, respectively. Saprolegnia parasitica and Aphanomyces euteiches were used as outgroup taxa. Scale bar indicates 0.1 expected changes per site per branch.
Across a 5-partition (LSU–ITS–βtub–cox1–cox2) alignment (4209 characters), S. medusiformis showed pairwise differences from its closest relative Pilasporangium apinafurcum at 614 positions, equivalent to a genetic distance of 14.6%. With 204 polymorphisms and 103 indels across a 788 bp alignment, differences were considerably higher (39.0%) in the ITS region with its non–coding parts than in the coding genes LSU (1260 bp; 86 polymorphic sites; 6.8% difference); βtub (918 bp; 99 polymorphisms and 6 indels; 11.4%); cox1 (680 bp; 64 polymorphisms; 9.4%); and cox2 (563 bp; 52 polymorphisms; 9.2%).
3.2. Taxonomy
Synchrospora T. Jung, Y. Balci, K. Broders and M. Horta Jung, gen. nov. MycoBank MB 847829.
Etymology. Name refers to the synchronous production of numerous sporangia from one sporangiophore apex.
Type species. Synchrospora medusiformis.
In the only known species, Synchrospora medusiformis, sporangiophores are usually unbranched or infrequently have a short lateral branch, showing determinate growth multifurcating at the end in a subdichotomous way, forming a stunted, candelabra-like apex from which multiple (8 to >100) long arch- or hook-like curved pedicels grow and form the sporangia in a synchronous way, resulting in a multi-sporangia structure with a medusa-like appearance. Sporangia are narrow and elongated, mostly cylindrical to allantoid, usually with an asymmetric base and a papillate apex when mature, and caducous. After shedding, the pedicels usually become twisted. Sporangia germinate directly with multiple hyphae or indirectly by releasing 2–5 biflagellate zoospores through a very narrow exit pore without a discharge tube. No internal sporangial proliferation was observed. Very rarely, external proliferation of the sporangiophore occurs some distance from the apex. Chlamydospores are not formed. The breeding system is homothallic and, hence, predominantly inbreeding, forming smooth-walled oogonia, containing plerotic thick-walled oospores with a large lipid globule, and paragynous antheridia. Hyphae often show undulating growth. Phylogenetically, Synchrospora belongs to the Peronosporaceae within the Peronosporales.
Synchrospora medusiformis T. Jung, Y. Balci, K. Broders and I. Milenković, sp. nov.

Figure 2.
Morphological structures of Synchrospora medusiformis formed on V8 agar flooded with soil extract. (A–D) Candelabra-like branching of sporangiophore apices; (E,F) beginning growth of sporangial pedicels (arrows) from sporangiophore apices; (G–J) progressive growth of initially straight sporangial pedicels from sporangiophore apices. Scale bar: 15 µm.

Figure 3.
Morphological structures of Synchrospora medusiformis formed on V8 agar flooded with soil extract. (A,B) progressive growth of initially straight sporangial pedicels from sporangiophore apices; (C–G) progressive growth of increasingly curved, arch-like sporangial pedicels from sporangiophore apices. Scale bar: 25 µm.

Figure 4.
Morphological structures of Synchrospora medusiformis formed on V8 agar flooded with soil extract. (A–F) Medusa-like appearance of sporangiophore apices (arrows) with numerous long arch- or hook-like pedicels; (A–D) progressive formation of initially non-papillate sporangia at the ends of unbranched pedicels; (E,F) mature, papillate allantoid to tubular sporangia. Scale bar: 25 µm.

Figure 5.
Morphological structures of Synchrospora medusiformis formed on V8 agar flooded with soil extract. (A–E) Mature, papillate, allantoid sporangia; (A–D) caducous with mostly curved or twisted long pedicels; (E) beginning direct germination (arrows); (F,G) allantoid sporangia releasing zoospores; (H) empty limoniform sporangium after zoospore release; (I–K) motile heterokont zoospores with each two flagella of unequal length (arrows). Scale bar: 25 µm.
Etymology: The name refers to the medusa-like appearance of the sporangiophore apex with multiple sporangia on long arch-like pedicels.
Holotype: Panama, Province Chiriqui, Volcano Barú, isolated from a naturally fallen leaf of an unidentified tree species in a tropical cloud forest at an altitude of 2393 m. Collected: K. Broders and Y. Balci, November 2019; CBS H-24948 (holotype, dried culture on V8A, Herbarium CBS–KNAW Fungal Biodiversity Centre), CBS 149011 = PA229 (ex-type culture). ITS, βtub, LSU, cox1 and cox2 sequences GenBank accession nos. OQ600177, OQ605385, OQ600184, OQ605396 and OQ605417, respectively.
Description: Sporangiophores were not observed in solid agar but were produced abundantly in non-sterile soil extract. They were usually unbranched or infrequently formed short lateral hyphae. Sporangiophores showed determinate growth and were always multifurcating at the end, forming a stunted, candelabra-like apex from which multiple (8 to >100) pedicels were growing simultaneously (Figure 2 and Figure 3). All sporangia at the end of the fully elongated pedicels from a sporangiophore apex were formed in a synchronous way, giving the mature multi-sporangia structure a medusa-like appearance (Figure 4). Sporangia were elongated, mostly cylindrical to allantoid (Figure 4 and Figure 5A–G) or very rarely limoniform (Figure 5h), usually with an asymmetric curved base and a papillate apex when mature (Figure 4E,F and Figure 5A–E). Sporangial dimensions of five isolates of S. medusiformis averaged 22.3 ± 2.6 × 7.2 ± 0.7 µm (overall range 15.8–31.6 × 5.5–9.2 µm), with a range of isolate means of 21.0–23.0 × 7.1–7.4 µm and a length/breadth ratio of 3.1 ± 0.4 (range of isolate means 2.96–3.21). Pedicels were arch-like or hook-like curved when still attached to the sporangiophore apex (Figure 3 and Figure 4). Pedicel length was 58.0 ± 9.6 µm (overall range 35.3–89.7 µm; range of isolate means 53.2–61.7 µm). All sporangia arising from a sporangiophore apex were caducous and shed more or less synchronously (Figure 5A–E). After shedding, the pedicels often became twisted (Figure 5A–E). Sporangia germinated directly with multiple hyphae (Figure 5E) or indirectly by releasing two to three (in rare cases up to five) zoospores through a very narrow exit pore (1.6 ± 0.2 µm) without a discharge tube (Figure 5F–H). Zoospores were heterokont biflagellate with one longer flagellum and one shorter flagellum and limoniform to reniform whilst motile (Figure 5I–K), becoming spherical (av. diam = 8.5 ± 1.1 µm) on encystment. No internal sporangial proliferation occurred. Very rarely, branching of the sporangiophore some distance from the apex was observed (Figure 4C).
All five isolates of S. medusiformis were homothallic. Gametangia were produced in single culture in V8A within 10–14 d. Oogonia were borne terminally or laterally, had smooth walls and thin stalks and were globose with round, non-tapering bases (Figure 6A–R). The mean diameter of oogonia was 27.6 ± 2.9 µm (overall range 16.7–45.0 µm and range of isolate means 25.6–29.9 µm). They were exclusively plerotic, filling the oogonia completely and making a distinction between the oogonium and oospore walls in most cases impossible (Figure 6A–R). The oospores were globose with large lipid globules (=ooplasts), turning golden-brown during maturation (Figure 6A–R), and had a diameter of 26.0 ± 2.9 µm (overall range 15.1–38.8 µm), a wall diameter of 1.44 ± 0.19 µm (range 0.87–2.37 µm) and an oospore wall index of 0.30 ± 0.03. Oospore abortion was low (12.6% after 4 weeks). The antheridia were exclusively paragynous, club-shaped to subglobose, cylindrical or irregular (Figure 6A–R) and averaged 10.8 ± 2.4 × 6.1 ± 1.5 µm.

Figure 6.
Morphological structures of Synchrospora medusiformis formed in solid V8 agar. (A–R) Mature, golden-brown, smooth–walled globose oogonia formed in single culture on very thin stalks, containing thick–walled fully plerotic oospores with large lipid globules (ooplasts), with one or sometimes two paragynous antheridia (arrows); (S,T) undulating hyphae without basal constrictions. Scale bar: 25 µm.
Hyphae often showed undulating growth (Figure 6S,T).
Colony morphology, growth rates and cardinal temperatures: Colonies of S. medusiformis on V8A and CA were largely submerged with limited aerial mycelium, with a petaloid pattern on V8A and a chrysanthemum pattern on CA. On PDA, colonies were densely felty with petaloid to stoloniferous patterns (Figure 7). Temperature–growth relations on V8A are shown in Figure 8. All five isolates included in the growth test had similar growth rates and cardinal temperatures. The maximum growth temperature was between 25 and 27.5 °C. The ex-type isolate (CBS 149011) did not resume growth when plates incubated for 7 d at 27.5 °C were transferred to 20 °C. The other four isolates did not resume growth when plates incubated for 7 d at 30 °C were transferred to 20 °C. The average radial growth rate on V8A at the optimum temperature of 22.5 °C was 12.5 ± 0.58 mm/d (isolate range 11.5–13.0 mm/d; Figure 8).
Figure 7.
Colony morphology of Synchrospora medusiformis isolates CBS 149011, PA230 and PA231 (from left to right) after 7 d growth at 20 ºC on V8 agar, carrot agar, potato–dextrose agar and malt extract agar (from top to bottom).

Figure 8.
Mean radial growth rates of five isolates of Synchrospora medusiformis on V8 agar at different temperatures.
Other specimens examined (paratypes): Panama, Province Chiriqui, Volcán Barú, isolated from naturally fallen leaves of unidentified tree species in a tropical cloud forest at an altitude of 2393 m. Collected: K. Broders and Y. Balci, November 2019; PA228, PA230, PA231, PA232.
Notes: The only known species of the new genus Synchrospora, S. medusiformis, is differentiated from all other known oomycete species by its unique synchronous production of numerous (up to >100) caducous, long-pedicellate sporangia per multifurcating candelabra-like apex of sporangiophores with determinate growth enabling simultaneous aerial spread. In contrast, all aerial species of Phytophthora and Nothophytophthora produce sporangia individually on unbranched sporangiophores or consecutively on indeterminate sporangiophores, forming lax simple sympodia or dense compound sympodia [6,8,16,26,31,34,36]. Furthermore, the sporangia of S. medusiformis were, on average, smaller than in any known Phytophthora and Nothophytophthora species. Like S. medusiformis, all but two of the 20 known downy mildew (DM) genera also show determinate sporangiophore growth (Viennotia being the exception) and simultaneously ripening sporangia (Sclerophthora being the exception) [119]. Moreover, in several DM genera, the determinate sporangiophores also have dilated apices on which multiple sporangia or conidia are produced. These apices are saucer-shaped in Bremia, club-shaped in Eraphthora, cone- to club-shaped in Basidiophora and broad club-shaped to cylindrical in Baobabopsis [120,121,122,123]. However, none of the known DM genera form multifurcated candelabra-like sporangiophore apices. In addition, the pedicels of S. medusiformis are much longer than in any known DM species, and none of the known DM genera produce up to 100 or more sporangia per apex. Finally, the DMs are phylogenetically distant from Synchrospora, residing as two distinct clades within the paraphyletic genus Phytophthora [7,8,16], and are obligate biotrophic, nonculturable pathogens, whereas S. medusiformis grows well on various culture media.
4. Discussion
During a survey of oomycete diversity in natural forests of Central America, fast growing oomycete isolates were obtained alongside a diverse community of known and new Phytophthora, Phytopythium and Pythium species (Y. Balci, K. Broders and T. Jung, unpublished results), from naturally fallen tree leaves collected in a tropical cloud forest near the peak of Volcano Barú in Panama. Phylogenetic analyses of a five-partition dataset of sequences from the nuclear ITS, LSU and βtub genes and the mitochondrial cox1 and cox2 genes placed them into a distinct, previously unknown species belonging to a new genus described here as Synchrospora gen. nov. Based on its distinct phylogenetic position and unique set of morphological and physiological characteristics, the novel taxon is described here as S. medusiformis.
The multigene phylogenetic analysis demonstrated that Synchrospora resides in a basal position to a large cluster comprising all known Peronosporaceae genera, i.e., Calycofera, Halophytophthora, Nothophytophthora, Phytophthora (including the DMs) and Phytopythium [1,2,4,6,8,9,124]. Due to the phylogenetic position and the sporangial caducity of S. medusiformis, a common characteristic in the Peronosporaceae genera Nothophytophthora and Phytophthora including the DMs that has never been observed in any of the known Pythiaceae genera, Synchrospora is assigned to the Peronosporaceae constituting the basal genus of the family.
Despite the high number of oomycete surveys performed during the previous two decades in both managed and natural ecosystems across most continents, there is only one GenBank entry matching Synchrospora (ITS accession no. KM265501, 100% identical to S. medusiformis), which came from isolate E14413A (designated as Fungal sp. E14413A), obtained from stem tissue of the shrub species Croton alnifolius (Euphorbiaceae) during a fungal endophyte survey in a tropical cloud forest of Ecuador. This finding and the fact that all isolates of S. medusiformis examined in the present study originate from naturally fallen tree leaves in a remote tropical cloud forest near the peak of Volcano Barú in Panama suggest that this species is a neotropical canopy dweller in permanently humid cloud forests with a highly specialised aerial lifestyle as a leaf and bark pathogen.
Functionally, the synchronous production and ripening of up to more than 100 caducous sporangia per candelabra-like sporangiophore apex in S. medusiformis resembles 19 of the 20 DM genera [4,119,120,123,125,126,127], allowing simultaneous aerial spread with high inoculum pressure. Another similarity between Synchrospora and the DMs is the small size (and hence weight) of the sporangia increasing their aerial dispersibility, whereas the unusually long, curved and twisted pedicels most likely facilitate sporangial clustering and adherence to plant surfaces as recently suggested for aerial long-pedicellate Phytophthora species [16].
Synchrospora medusiformis, 75% of the eight described Nothophytophthora species, 26.7% of the 210 described Phytophthora species and all ca 900 DM species have caducous sporangia (or conidia) connected to an aerial or partially aerial lifestyle [4,6,13,14,16,31,34,36,123], whereas the other Peronosporaceae genera Calycofera, Halophytophthora and Phytopythium completely lack sporangial caducity [5,9,22,33]. Significant differences in sporangiophore growth and sporangial caducity between Synchrospora (determinate sporangiophores, synchronous production of up to >100 pedicellate caducous sporangia per candelabra-like sporangiophore apex); Nothophytophthora (indeterminate sporangiophores forming sympodia of non-pedicellate sporangia that mature non-synchronously; caducity by breaking off below a conspicuous opaque plug); Phytophthora (indeterminate sporangiophores forming sympodia of pedicellate sporangia that mature non-synchronously; caducity in airborne species); Viennotia (indeterminate sporangiophores, non-pedicellate caducous sporangia that mature non-synchronously); and the other 19 DM genera (determinate sporangiophores forming non-pedicellate or rarely pedicellate (cf. Basdiophora; [120]) caducous sporangia or conidia that mature synchronously) [3,4,6,16,26,34,36,119,123] suggest that sporangial caducity and an aerial or partially aerial lifestyle evolved independently in different Peronosporaceae genera in a convergent way.
During the past three decades, diversity of oomycete species and their ecological and pathogenic roles in soils and waterbodies of natural ecosystems have been studied extensively [29,37,38,39,40,43,44,45,46,49,50,51,52,53,54,57,60,65,67,68,70,73,75,76,78,80,82,83,84,85,87,88]. In contrast, there is only limited knowledge about the diversity and ecological roles of oomycetes in forest canopies, mainly gained from studies of often devastating diseases in temperate oceanic regions associated with (i) invasive aerial Phytophthora species like P. ramorum causing “Sudden Oak Death” in California and Oregon or “Sudden Larch Death” in the British Isles [43,48,62]; P. kernoviae causing aerial bark cankers on Fagus sylvatica in the UK [128]; P. pinifolia causing shoot and needle blight and defoliations of Pinus radiata in Chile [59]; P. pluvialis causing red needle cast of P. radiata in New Zealand [129] and branch and stem cankers and defoliations of Tsuga heterophylla in the UK [66]; or (ii) native aerial Phytophthora species like P. pseudosyringae causing bark cankers and dieback of exotic Nothofagus species in the UK [69]; P. nemorosa and P. siskiyouensis causing scattered bark cankers on Notholithocarpus densiflorus and other tree species in the Pacific Northwest [47]; and P. ilicis causing leaf, shoot and fruit blight on the native Ilex aquifolium in Sardinia, Italy [130]. Isolations from necrotic lesions of naturally fallen tree leaves indicate that in their centres of origin, P. ramorum (laurosilva forests in Vietnam and Japan); P. kernoviae and P. pseudokernoviae (Valdivian rainforests in Chile); and P. celebensis, P. javanensis and P. multiglobulosa (tropical rainforests in Indonesia) thrive in forest canopies as benign seasonal colonisers of senescent leaves [31,44,45,131,132]. Numerous leaf, shoot and fruit blights and canker diseases caused by aerial Phytophthora pathogens, including P. botryosa, P. capsici, P. heterospora, P. meadii, P. megakarya, P. palmivora and P. tropicalis, on tropical tree crops [8,26,133,134,135,136,137,138,139,140,141,142] and the findings of S. medusiformis on naturally fallen tree leaves and stem tissue in tropical cloud forests in Panama and Ecuador predict a rich community of aerial Phytophthoras and other oomycetes inhabiting tropical forest canopies. Extensive surveys in canopies of tropical lowland and montane forests using both isolation tests and metagenomic approaches from necrotic leaf, shoot, fruit and bark tissues, canopy-drip samples and spore traps are needed in both wet and dry seasons to unveil the diversity of tropical aerial oomycetes and their ecological roles and host associations.
The morphological and physiological attributes of P. parvispora provide insights into the ecology and survival strategy of this pathogen. Having high cardinal temperatures for growth >12, 27 and 37 °C, respectively, P. parvispora is well adapted to tropical and subtropical climates and greenhouse conditions, which is reflected by all known disease outbreaks.
Supplementary Materials
The following are available online at https://www.mdpi.com/article/10.3390/jof9050517/s1, Table S1: Details of isolates from Synchrospora and related oomycete genera considered in the phylogenetic studies.
Author Contributions
Conceptualisation, T.J., Y.B. and M.H.J.; methodology, Y.B., M.H.J., T.K. and T.J.; formal analysis, Y.B., T.J., K.D.B., I.M., B.Đ., J.J., T.K. and M.H.J.; investigation, Y.B., T.J., K.D.B., I.M. and M.H.J.; data curation, T.J. and M.H.J.; writing—original draft preparation, T.J. and M.H.J.; writing—review and editing, T.J., M.H.J., Y.B., K.D.B., I.M., J.J., B.Đ. J.J. and T.K.; funding acquisition, T.J. and M.H.J. All authors have read and agreed to the published version of the manuscript.
Funding
This study was supported by the Project Phytophthora Research Centre Reg. No. CZ.02.1.01/0.0/0.0/15_003/0000453, financed by the Czech Ministry for Education, Youth and Sports and the European Regional Development Fund.
Institutional Review Board Statement
Not applicable.
Informed Consent Statement
Not applicable.
Data Availability Statement
All sequences generated during this study are available from GenBank, and accession numbers are given in Table S1. All datasets and trees derived from BI and ML analyses are available from DRYAD (https://datadryad.org, accessed on 24 April 2023) (Dryad Dataset, https://doi.org/10.5061/dryad.p2ngf1vvt).
Acknowledgments
We thank Aneta Bačová, Anna Hýsková, Henrieta Ďatková and Milica Raco (all at Mendel University in Brno, Czech Republic) for much appreciated technical support.
Conflicts of Interest
The authors declare no conflict of interest.
References
- Dick, M.W. Straminipilous fungi: Systematics of the Peronosporomycetes Including Accounts of the Marine Straminipilous Protists, the Plasmodiophorids and Similar Organisms; Kluwer: Dordrecht, The Netherlands, 2001. [Google Scholar]
- Hulvey, J.; Telle, S.; Nigrelli, L.; Lamour, K.; Thines, M. Salisapiliaceae—A new family of oomycetes from marsh grass litter of southeastern North America. Persoonia 2010, 25, 109–116. [Google Scholar] [CrossRef] [PubMed]
- Beakes, G.W.; Honda, T.; Thines, M. Systematics of the Stramenipila: Labyrinthulomycota, Hyphochytridiomycota, and Oomycota. In Systematics and Evolution; McLaughlin, D.J., Spatafora, J., Eds.; Springer: New York, NY, USA, 2014; pp. 39–97. [Google Scholar]
- Thines, M.; Choi, Y.-J. Evolution, diversity and taxonomy of the Peronosporaceae, with focus on the genus Peronospora. Phytopathology 2016, 106, 6–18. [Google Scholar] [CrossRef] [PubMed]
- Bennett, R.M.; de Cock, A.W.A.M.; Lévesque, A.; Thines, M. Calycofera gen. nov., an estuarine sister taxon to Phytopythium, Peronosporaceae. Mycol. Prog. 2017, 16, 947–954. [Google Scholar] [CrossRef]
- Jung, T.; Scanu, B.; Bakonyi, J.; Seress, D.; Kovács, G.M.; Durán, A.; Sanfuentes von Stowasser, E.; Schena, L.; Mosca, S.; Thu, P.Q.; et al. Nothophytophthora gen. nov., a new sister genus of Phytophthora from natural and semi-natural ecosystems. Persoonia 2017, 39, 143–174. [Google Scholar] [CrossRef]
- Bourret, T.B.; Choudhury, R.A.; Mehl, H.K.; Blomquist, C.L.; McRoberts, N.; Rizzo, D.M. Multiple origins of downy mildews and mito-nuclear discordance within the paraphyletic genus Phytophthora. PLoS ONE 2018, 13, e0192502. [Google Scholar] [CrossRef]
- Scanu, B.; Jung, T.; Masigol, H.; Linaldeddu, B.T.; Horta Jung, M.; Brandano, A.; Mostowfizadeh-Ghalamfarsa, R.; Janoušek, J.; Riolo, M.; Cacciola, S.O. Phytophthora heterospora sp. nov., a new pseudoconidia-producing sister species of P. palmivora. J. Fungi 2021, 7, 870. [Google Scholar] [CrossRef]
- Maia, C.; Horta Jung, M.; Carella, G.; Milenković, I.; Janoušek, J.; Tomšovský, M.; Mosca, S.; Schena, L.; Cravador, A.; Moricca, S.; et al. Eight new Halophytophthora species from marine and brackish-water ecosystems in Portugal and an updated phylogeny for the genus. Persoonia 2022, 48, 54–90. [Google Scholar] [CrossRef]
- Cooke, D.E.L.; Drenth, A.; Duncan, J.M.; Wagels, G.; Brasier, C.M. A molecular phylogeny of Phytophthora and related oomycetes. Fungal Genet. Biol. 2000, 30, 17–32. [Google Scholar] [CrossRef]
- Riethmüller, A.; Voglmayr, H.; Göker, M.; Weiß, M.; Oberwinkler, F. Phylogenetic relationships of the downy mildews (Peronosporales) and related groups based on nuclear large subunit ribosomal DNA sequences. Mycologia 2002, 94, 834–849. [Google Scholar] [CrossRef]
- Kroon, L.P.N.M.; Bakker, F.T.; van den Bosch, G.B.M.; Bonants, P.J.M.; Flier, W.G. Phylogenetic analysis of Phytophthora species based on mitochondrial and nuclear DNA sequences. Fungal Genet. Biol. 2004, 41, 766–782. [Google Scholar] [CrossRef]
- Göker, M.; Voglmayer, H.; Riethmüller, A.; Oberwinkler, F. How do obligate parasites evolve? A multi–gene phylogenetic analysis of downy mildews. Fungal Genet. Biol. 2007, 44, 105–122. [Google Scholar] [CrossRef]
- Runge, F.; Telle, S.; Ploch, S.; Savory, E.; Day, B.; Sharma, R.; Thines, M. The inclusion of downy mildews in a multi–locus–dataset and its reanalysis reveals a high degree of paraphyly in Phytophthora. IMA Fungus 2011, 2, 163–171. [Google Scholar] [CrossRef]
- Martin, F.N.; Blair, J.E.; Coffey, M.D. A combined mitochondrial and nuclear multilocus phylogeny of the genus Phytophthora. Fungal Genet. Biol. 2014, 66, 19–32. [Google Scholar] [CrossRef]
- Brasier, C.; Scanu, B.; Cooke, D.; Jung, T. Phytophthora: An ancient, historic, biologically and structurally cohesive and evolutionarily successful generic concept in need of preservation. IMA Fungus 2022, 13, 12. [Google Scholar] [CrossRef]
- Briard, M.; Dutertre, M.; Rouxel, F.; Brygoo, Y. Ribosomal RNA sequence divergence within the Pythiaceae. Mycol. Res. 1995, 99, 1119–1127. [Google Scholar] [CrossRef]
- de Cock, A.W.A.M.; Lévesque, C.A. New species of Pythium and Phytophthora. Stud. Mycol. 2004, 50, 481–487. [Google Scholar]
- Villa, N.O.; Kageyama, K.; Asano, T.; Suga, H. Phylogenetic relationships of Pythium and Phytophthora species based on ITS rDNA, cytochrome oxidase II and beta–tubulin gene sequences. Mycologia 2006, 98, 410–422. [Google Scholar] [PubMed]
- Bala, K.; Robideau, G.P.; Lévesque, C.A.; de Cock, A.W.A.M.; Abad, Z.G.; Lodhi, A.M.; Shahzad, S.; Ghaffar, A.; Coffey, M.D. Phytopythium Abad, de Cock, Bala, Robideau, Lodhi & Lévesque, gen. nov. and Phytopythium sindhum Lodhi, Shahzad & Lévesque, sp. nov. Fungal Planet 49. Persoonia 2010, 24, 136–137. [Google Scholar]
- Uzuhashi, S.; Tojo, M.; Kakishima, M. Phylogeny of the genus Pythium and description of new genera. Mycoscience 2010, 51, 337–365. [Google Scholar] [CrossRef]
- de Cock, A.W.A.M.; Lodhi, A.M.; Rintoul, T.L.; Bala, K.; Robideau, G.P.; Abad, Z.G.; Coffey, M.D.; Shahzad, S.; Lévesque, C.A. Phytopythium: Molecular phylogeny and systematics. Persoonia 2015, 34, 25–39. [Google Scholar] [CrossRef]
- Nguyen, H.D.T.; Dodge, A.; Dadej, K.; Rintoul, T.L.; Ponomareva, E.; Martin, F.N.; de Cock, A.W.A.M.; Lévesque, C.A.; Redhead, S.A.; Spies, C.F.J. Whole genome sequencing and phylogenomic analysis show support for the splitting of genus Pythium. Mycologia 2022, 114, 501–515. [Google Scholar] [CrossRef]
- Gäumann, E.A. The Fungi. A Description of Their Morphological Features and Evolutionary Development; Hafner Publishing: New York, NY, USA; London, UK, 1952. [Google Scholar]
- Newell, S.Y.; Fell, J.W. Do halophytophthoras (marine Pythiaceae) rapidly occupy fallen leaves by intraleaf mycelial growth? Can. J. Bot. 1995, 73, 761–765. [Google Scholar] [CrossRef]
- Erwin, D.C.; Ribeiro, O.K. Phytophthora Diseases Worldwide; APS Press: St. Paul, MN, USA, 1996. [Google Scholar]
- Leaño, E.M.; Jones, E.B.G.; Vrijmoed, L.L.P. Why are Halophytophthora species well adapted to mangrove habitats? Fungal Divers. 2000, 5, 131–151. [Google Scholar]
- Nakagiri, A. Ecology and biodiversity of Halophytophthora species. Fungal Divers. 2000, 5, 153–164. [Google Scholar]
- Brasier, C.M.; Cooke, D.E.L.; Duncan, J.M.; Hansen, E.M. Multiple new phenotypic taxa from trees and riparian ecosystems in Phytophthora gonapodyides–P. megasperma ITS Clade 6, which tend to be high-temperature tolerant and either inbreeding or sterile. Mycol. Res. 2003, 107, 277–290. [Google Scholar] [CrossRef]
- Jung, T.; Stukely, M.J.C.; Hardy, G.E.S.J.; White, D.; Paap, T.; Dunstan, W.A.; Burgess, T.I. Multiple new Phytophthora species from ITS Clade 6 associated with natural ecosystems in Australia: Evolutionary and ecological implications. Persoonia 2011, 26, 13–39. [Google Scholar] [CrossRef]
- Jung, T.; Milenković, I.; Corcobado, T.; Májek, T.; Janoušek, J.; Kudláček, T.; Tomšovský, M.; Nagy, Z.; Durán, A.; Tarigan, M.; et al. Extensive morphological and behavioural diversity among fourteen new and seven described species in Phytophthora Clade 10 and its evolutionary implications. Persoonia 2022, 49, 1–57. [Google Scholar] [CrossRef]
- Bennett, R.M.; Nam, B.; Dedeles, G.R.; Thines, M. Phytopythium leanoi sp. nov. and Phytopythium dogmae sp. nov., Phytopythium species associated with mangrove leaf litter from the Philippines. Acta Mycol. 2017, 52, 1103. [Google Scholar] [CrossRef]
- Jesus, A.L.; Marano, A.V.; Gonçalves, D.R.; Jerônimo, G.H.; Pires-Zottarelli, C.L.A. Two new species of Halophytophthora from Brazil. Mycol. Prog. 2019, 18, 1411–1421. [Google Scholar] [CrossRef]
- Chen, Q.; Bakhshi, M.; Balci, Y.; Broders, K.D.; Cheewangkoon, R.; Chen, S.F.; Fan, X.L.; Gramaje, D.; Halleen, F.; Horta Jung, M.; et al. Genera of phytopathogenic fungi: GOPHY 4. Stud. Mycol. 2022, 101, 417–564. [Google Scholar] [CrossRef]
- Beakes, G.W.; Glockling, S.L.; Sekimoto, S. The evolutionary phylogeny of the oomycete “fungi”. Protoplasma 2012, 249, 3–19. [Google Scholar] [CrossRef] [PubMed]
- O’Hanlon, R.; Destefanis, M.; Milenković, I.; Tomšovský, M.; Janoušek, J.; Bellgard, S.E.; Weir, B.S.; Kudláček, T.; Horta Jung, M.; Jung, T. Two new Nothophytophthora species from streams in Ireland and Northern Ireland: Nothophytophthora irlandica and N. lirii sp. nov. PLoS ONE 2021, 16, e0250527. [Google Scholar] [CrossRef] [PubMed]
- Brasier, C.M.; Robredo, F.; Ferraz, J.F.P. Evidence for Phytophthora cinnamomi involvement in Iberian oak decline. Plant Pathol. 1993, 42, 140–145. [Google Scholar] [CrossRef]
- Brasier, C.M.; Kirk, S.A.; Delcan, J.; Cooke, D.E.L.; Jung, T.; In’T Veld, W.A.M. Phytophthora alni sp. nov. and its variants: Designation of emerging heteroploid hybrid pathogens spreading on Alnus trees. Mycol. Res. 2004, 108, 1172–1184. [Google Scholar] [CrossRef]
- Jung, T.; Blaschke, H.; Neumann, P. Isolation, identification and pathogenicity of Phytophthora species from declining oak stands. Eur. J. For. Pathol. 1996, 26, 253–272. [Google Scholar] [CrossRef]
- Jung, T.; Blaschke, H.; Osswald, W. Involvement of soilborne Phytophthora species in Central European oak decline and the effect of site factors on the disease. Plant Pathol. 2000, 49, 706–718. [Google Scholar] [CrossRef]
- Jung, T.; Vettraino, A.M.; Cech, T.L.; Vannini, A. The impact of invasive Phytophthora species on European forests. In Phytophthora: A Global Perspective; Lamour, K., Ed.; CABI: Wallingford, UK, 2013; pp. 146–158. [Google Scholar]
- Jung, T.; Orlikowski, L.; Henricot, B.; Abad-Campos, P.; Aday, A.G.; Aguín Casal, O.; Bakonyi, J.; Cacciola, S.O.; Cech, T.; Chavarriaga, D.; et al. Widespread Phytophthora infestations in European nurseries put forest, semi–natural and horticultural ecosystems at high risk of Phytophthora diseases. For. Pathol. 2016, 46, 134–163. [Google Scholar] [CrossRef]
- Jung, T.; Pérez-Sierra, A.; Durán, A.; Horta Jung, M.; Balci, Y.; Scanu, B. Canker and decline diseases caused by soil- and airborne Phytophthora species in forests and woodlands. Persoonia 2018, 40, 182–220. [Google Scholar] [CrossRef]
- Jung, T.; Durán, A.; von Stowasser, E.S.; Schena, L.; Mosca, S.; Fajardo, S.; González, M.; Navarro Ortega, A.D.; Bakonyi, J.; Seress, D.; et al. Diversity of Phytophthora species in Valdivian rainforests and association with severe dieback symptoms. For. Pathol. 2018, 48, e12443. [Google Scholar] [CrossRef]
- Jung, T.; Scanu, B.; Brasier, C.M.; Webber, J.; Milenković, I.; Corcobado, T.; Tomšovský, T.; Pánek, M.; Bakonyi, J.; Maia, C.; et al. A survey in natural forest ecosystems of Vietnam reveals high diversity of both new and described Phytophthora taxa including P. ramorum. Forests 2020, 11, 93. [Google Scholar] [CrossRef]
- Hansen, E.M.; Goheen, D.J.; Jules, E.S.; Ullian, B. Managing Port–Orford–Cedar and the introduced pathogen Phytophthora lateralis. Plant Dis. 2000, 84, 4–14. [Google Scholar] [CrossRef]
- Hansen, E.M.; Reeser, P.W.; Sutton, W. Phytophthora beyond agriculture. Annu. Rev. Phytopathol. 2012, 50, 359–378. [Google Scholar] [CrossRef]
- Rizzo, D.M.; Garbelotto, M.; Davidson, J.M.; Slaughter, G.W.; Koike, S.T. Phytophthora ramorum as the cause of extensive mortality of Quercus spp. and Lithocarpus densiflorus in California. Plant Dis. 2002, 86, 205–214. [Google Scholar] [CrossRef]
- Vettraino, A.M.; Barzanti, G.P.; Bianco, M.C.; Ragazzi, A.; Capretti, P.; Paoletti, E.; Luisi, N.; Anselmi, N.; Vannini, A. Occurrence of Phytophthora species in oak stands in Italy and their association with declining oak trees. For. Pathol. 2002, 32, 19–28. [Google Scholar] [CrossRef]
- Vettraino, A.M.; Morel, O.; Perlerou, C.; Robin, C.; Diamandis, S.; Vannini, A. Occurrence and distribution of Phytophthora species associated with Ink Disease of chestnut in Europe. Eur. J. Plant Pathol. 2005, 111, 169–180. [Google Scholar] [CrossRef]
- Balci, Y.; Halmschlager, E. Incidence of Phytophthora species in oak forests in Austria and their possible involvement in oak decline. For. Pathol. 2003, 33, 157–174. [Google Scholar] [CrossRef]
- Balci, Y.; Halmschlager, E. Phytophthora species in oak ecosystems in Turkey and their association with declining oak trees. Plant Pathol. 2003, 52, 694–702. [Google Scholar] [CrossRef]
- Jönsson, U.; Lundberg, L.; Sonesson, K.; Jung, T. First records of soilborne Phytophthora species in Swedish oak forests. For. Pathol. 2003, 33, 175–179. [Google Scholar] [CrossRef]
- Jung, T.; Blaschke, M. Phytophthora root and collar rot of alders in Bavaria: Distribution, modes of spread and possible management strategies. Plant Pathol. 2004, 53, 197–208. [Google Scholar] [CrossRef]
- Hardham, A.R. Phytophthora cinnamomi. Mol. Plant Pathol. 2005, 6, 589–604. [Google Scholar] [CrossRef]
- Balci, Y.; Balci, S.; Eggers, J.; MacDonald, W.L.; Juzwik, J.; Long, R.P.; Gottschalk, K.W. Phytophthora spp. associated with forest soils in Eastern and North–Central U.S. oak ecosystems. Plant Dis. 2007, 91, 705–710. [Google Scholar] [CrossRef] [PubMed]
- Balci, Y.; Long, R.P.; Mansfield, M.; Balser, D.; MacDonald, W.L. Involvement of Phytophthora species in white oak (Quercus alba) decline in southern Ohio. For. Pathol. 2010, 40, 430–442. [Google Scholar] [CrossRef]
- Greslebin, A.; Hansen, E.M.; Sutton, W. Phytophthora austrocedrae sp. nov., a new species associated with Austrocedrus chilensis mortality in Patagonia (Argentina). Mycol. Res. 2007, 111, 308–316. [Google Scholar] [CrossRef] [PubMed]
- Durán, A.; Gryzenhout, M.; Slippers, B.; Ahumada, R.; Rotella, A.; Flores, F.; Wingfield, B.D.; Wingfield, M.J. Phytophthora pinifolia sp. nov. associated with a serious needle disease of Pinus radiata in Chile. Plant Pathol. 2008, 57, 715–727. [Google Scholar] [CrossRef]
- Jung, T. Beech decline in Central Europe driven by the interaction between Phytophthora infections and climatic extremes. For. Pathol. 2009, 39, 73–94. [Google Scholar] [CrossRef]
- Jung, T.; Burgess, T.I. Re-evaluation of Phytophthora citricola isolates from multiple woody hosts in Europe and North America reveals a new species, Phytophthora plurivora sp. nov. Persoonia 2009, 22, 95–110. [Google Scholar] [CrossRef]
- Brasier, C.; Webber, J. Sudden larch death. Nature 2010, 466, 824–825. [Google Scholar] [CrossRef]
- Green, S.; Brasier, C.M.; Schlenzig, A.; McCracken, A.; MacAskill, G.A.; Wilson, M.; Webber, J.F. The destructive invasive pathogen Phytophthora lateralis found on Chamaecyparis lawsoniana across the UK. For. Pathol. 2013, 43, 19–28. [Google Scholar]
- Green, S.; Elliot, M.; Armstrong, A.; Hendry, S.J. Phytophthora austrocedrae emerges as a serious threat to juniper (Juniperus communis) in Britain. Plant Pathol. 2015, 64, 456–466. [Google Scholar] [CrossRef]
- Pérez-Sierra, A.; López-García, C.; León, M.; García-Jiménez, J.; Abad-Campos, P.; Jung, T. Previously unrecorded low temperature Phytophthora species associated with Quercus decline in a Mediterranean forest in Eastern Spain. For. Pathol. 2013, 43, 331–339. [Google Scholar] [CrossRef]
- Pérez-Sierra, A.; Chitty, R.; Eacock, A.; Jones, B.; Biddle, M.; Crampton, M.; Lewis, A.; Olivieri, L.; Webber, J.F. First report of Phytophthora pluvialis in Europe causing resinous cankers on western hemlock. New Dis. Rep. 2022, 45, e12064. [Google Scholar] [CrossRef]
- Ginetti, B.; Moricca, S.; Squires, J.N.; Cooke, D.E.L.; Ragazzi, A.; Jung, T. Phytophthora acerina sp. nov., a new species causing bleeding cankers and dieback of Acer pseudoplatanus trees in planted forests in Northern Italy. Plant Pathol. 2014, 63, 858–876. [Google Scholar] [CrossRef]
- Scanu, B.; Linaldeddu, B.T.; Deidda, A.; Jung, T. Diversity of Phytophthora species from declining Mediterranean maquis vegetation, including two new species, Phytophthora crassamura and P. ornamentata sp. nov. PLoS ONE 2015, 10, e0143234. [Google Scholar] [CrossRef]
- Scanu, B.; Webber, J.F. Dieback and mortality of Nothofagus in Britain: Ecology, pathogenicity and sporulation potential of the causal agent Phytophthora pseudosyringae. Plant Pathol. 2016, 65, 26–36. [Google Scholar] [CrossRef]
- Milenković, I.; Keča, N.; Karadžić, D.; Radulović, Z.; Nowakowska, J.A.; Oszako, T.; Sikora, K.; Corcobado, T.; Jung, T. Isolation and pathogenicity of Phytophthora species from poplar plantations in Serbia. Forests 2018, 9, 330. [Google Scholar] [CrossRef]
- Corcobado, T.; Cech, T.L.; Brandstetter, M.; Daxer, A.; Hüttler, C.; Kudláček, T.; Horta Jung, M.; Jung, T. Decline of European beech in Austria: Involvement of Phytophthora spp. and contributing biotic and abiotic factors. Forests 2020, 11, 895. [Google Scholar] [CrossRef]
- Jung, T.; Hansen, E.M.; Winton, L.; Oßwald, W.; Delatour, C. Three new species of Phytophthora from European oak forests. Mycol. Res. 2002, 106, 397–411. [Google Scholar] [CrossRef]
- Jung, T.; Chang, T.T.; Bakonyi, J.; Seress, D.; Pérez-Sierra, A.; Yang, X.; Hong, C.; Scanu, B.; Fu, C.H.; Hsueh, K.-L.; et al. Diversity of Phytophthora species in natural ecosystems of Taiwan and association with disease symptoms. Plant Pathol. 2017, 66, 194–211. [Google Scholar] [CrossRef]
- Jung, T.; Horta Jung, M.; Scanu, B.; Seress, D.; Kovács, D.M.; Maia, C.; Pérez-Sierra, A.; Chang, T.-T.; Chandelier, A.; Heungens, A.; et al. Six new Phytophthora species from ITS Clade 7a including two sexually functional heterothallic hybrid species detected in natural ecosystems in Taiwan. Persoonia 2017, 38, 100–135. [Google Scholar] [CrossRef]
- Jung, T.; Horta Jung, M.; Cacciola, S.O.; Cech, T.; Bakonyi, J.; Seress, D.; Mosca, S.; Schena, L.; Seddaiu, S.; Pane, A.; et al. Multiple new cryptic pathogenic Phytophthora species from Fagaceae forests in Austria, Italy and Portugal. IMA Fungus 2017, 8, 219–244. [Google Scholar] [CrossRef]
- Jung, T.; La Spada, F.; Pane, A.; Aloi, F.; Evoli, M.; Horta Jung, M.; Scanu, B.; Faedda, R.; Rizza, C.; Puglisi, I.; et al. Diversity and distribution of Phytophthora species in protected natural areas in Sicily. Forests 2019, 10, 259. [Google Scholar] [CrossRef]
- Zeng, H.-C.; Ho, H.-H.; Zheng, F.-C. A survey of Phytophthora species on Hainan Island of South China. J. Phytopathol. 2009, 157, 33–39. [Google Scholar] [CrossRef]
- Brasier, C.M.; Vettraino, A.M.; Chang, T.T.; Vannini, A. Phytophthora lateralis discovered in an old growth Chamaecyparis forest in Taiwan. Plant Pathol. 2010, 59, 595–603. [Google Scholar] [CrossRef]
- Rea, A.J.; Burgess, T.I.; Hardy, G.E.S.J.; Stukely, M.J.C.; Jung, T. Two novel and potentially endemic species of Phytophthora associated with episodic dieback of kwongan vegetation in the south–west of Western Australia. Plant Pathol. 2011, 60, 1055–1068. [Google Scholar] [CrossRef]
- Reeser, P.W.; Sutton, W.; Hansen, E.M.; Remigi, P.; Adams, G.C. Phytophthora species in forest streams in Oregon and Alaska. Mycologia 2011, 103, 22–35. [Google Scholar] [CrossRef]
- Vettraino, A.M.; Brasier, C.M.; Brown, A.V.; Vannini, A. Phytophthora himalsilva sp. nov. an unusually phenotypically variable species from a remote forest in Nepal. Fungal Biol. 2011, 115, 275–287. [Google Scholar] [CrossRef]
- Huai, W.X.; Tian, G.; Hansen, E.M.; Zhao, W.-X.; Goheen, E.M.; Grünwald, N.J.; Cheng, C. Identification of Phytophthora species baited and isolated from forest soil and streams in northwestern Yunnan province, China. For. Pathol. 2013, 43, 87–103. [Google Scholar] [CrossRef]
- Huberli, D.; Hardy, G.E.S.J.; White, D.; Williams, N.; Burgess, T.I. Fishing for Phytophthora from Western Australia’ s waterways: A distribution and diversity survey. Australas. Plant Pathol. 2013, 42, 251–260. [Google Scholar] [CrossRef]
- Oh, E.; Gryzenhout, M.; Wingfield, B.D.; Wingfield, M.J.; Burgess, T.I. Surveys of soil and water reveal a goldmine of Phytophthora diversity in South African natural ecosystems. IMA Fungus 2013, 4, 123–131. [Google Scholar] [CrossRef]
- Shrestha, S.K.; Zhou, Y.; Lamour, K. Oomycetes baited from streams in Tennessee 2010–2012. Mycologia 2013, 105, 1516–1523. [Google Scholar] [CrossRef]
- Català, S.; Peréz–Sierra, A.; Abad-Campos, P. The use of genus–specific amplicon pyrosequencing to assess Phytophthora species diversity using eDNA from soil and water in Northern Spain. PLoS ONE 2015, 10, e0119311. [Google Scholar] [CrossRef]
- Brazee, N.J.; Wick, R.L.; Hulvey, J.P. Phytophthora species recovered from the Connecticut River Valley in Massachusetts, USA. Mycologia 2016, 108, 6–19. [Google Scholar] [CrossRef]
- Dunstan, W.A.; Howard, K.; Hardy, G.E.S.J.; Burgess, T.I. An overview of Australia’s Phytophthora species assemblage in natural ecosystems recovered from a survey in Victoria. IMA Fungus 2016, 7, 47–58. [Google Scholar] [CrossRef]
- O’Hanlon, R.; Choiseul, J.; Corrigan, M.; Catarame, T.; Destefanis, M. Diversity and detections of Phytophthora species from trade and nontrade environments in Ireland. Bull. OEPP 2016, 46, 594–602. [Google Scholar] [CrossRef]
- Burgess, T.I.; White, D.; McDougall, K.M.; Garnas, J.; Dunstan, W.A.; Català, S.; Carnegie, A.J.; Worboys, S.; Cahill, D.; Vettraino, A.-M.; et al. Distribution and diversity of Phytophthora across Australia. Pac. Conserv. Biol. 2017, 23, 1–13. [Google Scholar] [CrossRef]
- Burgess, T.I.; Simamora, A.V.; White, D.; Williams, B.; Schwager, M.; Stukely, M.J.C.; Hardy, G.E.S.J. New species from Phytophthora Clade 6a: Evidence for recent radiation. Persoonia 2018, 41, 1–17. [Google Scholar] [CrossRef]
- Burgess, T.I.; Dang, Q.N.; Le, B.V.; Pham, N.Q.; White, D.; Pham, T.Q. Phytophthora acaciivora sp. nov. associated with dying Acacia mangium in Vietnam. FUSE 2020, 6, 243–252. [Google Scholar] [CrossRef]
- Bose, T.; Hulbert, J.M.; Burgess, T.I.; Paap, T.; Roets, F.; Wingfield, M.J. Two novel Phytophthora species from the southern tip of Africa. Mycol. Prog. 2021, 20, 755–767. [Google Scholar] [CrossRef]
- Dang, Q.N.; Pham, T.Q.; Arentz, F.; Hardy, G.E.S.J.; Burgess, T.I. New Phytophthora species in clade 2a from the Asia-Pacific region including a re-examination of P. colocasiae and P. meadii. Mycol. Prog. 2021, 20, 111–129. [Google Scholar] [CrossRef]
- Katoh, K.; Standley, D.M. MAFFT multiple sequence alignment software version 7: Improvements in performance and usability. Mol. Biol. Evol. 2013, 30, 772–780. [Google Scholar] [CrossRef]
- Lanfear, R.; Frandsen, P.; Wright, A.; Senfeld, T.; Calcott, B. PartitionFinder 2: New methods for selecting partitioned models of evolution for molecular and morphological phylogenetic analyses. Mol. Biol. Evol. 2016, 34, 772–773. [Google Scholar] [CrossRef] [PubMed]
- Kozlov, A.; Darriba, D.; Flouri, T.; Morel, B.; Stamatakis, A. RAxML-NG: A fast, scalable and user-friendly tool for maximum likelihood phylogenetic inference. Bioinformatics 2019, 35, 4453–4455. [Google Scholar] [CrossRef] [PubMed]
- Pattengale, N.; Alipour, M.; Bininda-Emonds, O.; Moret, B.; Stamatakis, A. How many bootstrap replicates are necessary? J. Comput. Biol. 2010, 17, 337–354. [Google Scholar] [CrossRef] [PubMed]
- Lemoine, F.; Domelevo Entfellner, J.; Wilkinson, E.; Correia, D.; Dávila Felipe, M.; De Oliveira, T.; Gascuel, O. Renewing Felsenstein’s phylogenetic bootstrap in the era of big data. Nature 2018, 556, 452–456. [Google Scholar] [CrossRef]
- Sukumaran, J.; Holder, M.T. DendroPy: A Python library for phylogenetic computing. Bioinformatics 2010, 26, 1569–1571. [Google Scholar] [CrossRef]
- Müller, N.; Bouckaert, R. Adaptive parallel tempering for BEAST 2. bioRxiv 2019, 603514. [Google Scholar] [CrossRef]
- Kone, A.; Kofke, D.A. Selection of temperature intervals for parallel-tempering simulations. J. Chem. Phys. 2005, 122, 1–2. [Google Scholar] [CrossRef]
- Atchadé, Y.F.; Roberts, G.O.; Rosenthal, J.S. Towards optimal scaling of metropolis-coupled Markov chain Monte Carlo. Stat. Comput. 2011, 21, 555–568. [Google Scholar] [CrossRef]
- Bouckaert, R.; Drummond, A. bModelTest: Bayesian phylogenetic site model averaging and model comparison. BMC Evol. Biol. 2017, 17, 42. [Google Scholar] [CrossRef]
- Drummond, A.J.; Ho, S.Y.W.; Phillips, M.J.; Rambaut, A. Relaxed phylogenetics and dating with confidence. PLoS Biol. 2006, 4, 699–710. [Google Scholar] [CrossRef]
- Rambaut, A.; Drummond, A.; Xie, D.; Baele, G.; Suchard, M. Posterior summarization in Bayesian phylogenetics using Tracer 1.7. Syst. Biol. 2018, 67, 901–904. [Google Scholar] [CrossRef]
- Stöver, B.C.; Müller, K.F. TreeGraph 2: Combining and visualizing evidence from different phylogenetic analyses. BMC Bioinform. 2010, 11, 7. [Google Scholar] [CrossRef]
- Tamura, K.; Stecher, G.; Kumar, S. MEGA11: Molecular Evolutionary Genetics Analysis version 11. Mol. Biol. Evol. 2021, 38, 3022–3027. [Google Scholar] [CrossRef]
- Blair, J.E.; Coffey, M.D.; Park, S.-Y.; Greiser, D.M.; Kang, S. A multi-locus phylogeny for Phytophthora utilizing markers derived from complete genome sequences. Fungal Genet. Biol. 2008, 45, 266–277. [Google Scholar] [CrossRef]
- Robideau, G.P.; de Cock, A.W.A.M.; Coffey, M.D.; Voglmayr, H.; Brouwer, H.; Bala, K.; Chitty, D.W.; Désaulniers, N.; Eggertson, Q.A.; Gachon, C.M.M.; et al. DNA barcoding of oomycetes with cytochrome c oxidase subunit I and internal transcribed spacer. Mol. Ecol. Resour. 2011, 11, 1002–1011. [Google Scholar] [CrossRef]
- Martin, F.N. Phylogenetic relationships among some Pythium species inferred from sequence analysis of the mitochondrially encoded cytochrome oxidase II gene. Mycologia 2000, 92, 711–727. [Google Scholar] [CrossRef]
- Martin, F.N.; Tooley, P.W. Phylogenetic relationships among Phytophthora species inferred from sequence analysis of mitochondrially encoded cytochrome oxidase I and II genes. Mycologia 2003, 95, 269–284. [Google Scholar] [CrossRef]
- Hudspeth, D.S.S.; Nadler, S.A.; Hudspeth, M.E.S. A COX2 molecular phylogeny of the Peronosporomycetes. Mycologia 2000, 92, 674–684. [Google Scholar] [CrossRef]
- White, T.J.; Bruns, T.; Lee, S.; Taylor, J. Amplification and direct sequencing of fungal ribosomal RNA genes for phylogenetics. In PCR Protocols: A Guide to Methods and Applications; Innis, M.A., Gelfand, D.H., Sninsky, J.J., White, T.J., Eds.; Academic Press: San Diego, CA, USA, 1990; pp. 315–322. [Google Scholar]
- Garbelotto, M.M.; Lee, H.K.; Slaughter, G.; Popenuck, T.; Cobb, F.W.; Brunset, T.D. Heterokaryosis is not required for virulence of Heterobasidion annosum. Mycologia 1997, 89, 92–102. [Google Scholar] [CrossRef]
- Hopple, J.S.; Vilgalys, R. Phylogenetic relationships among coprinoid taxa and allies based on data from restriction site mapping of nuclear rDNA. Mycologia 1994, 86, 96–107. [Google Scholar] [CrossRef]
- Dick, M.W. Keys to Pythium; University of Reading Press: Reading, UK, 1990. [Google Scholar]
- Jung, T.; Cooke, D.E.L.; Blaschke, H.; Duncan, J.M.; Oßwald, W. Phytophthora quercina sp. nov., causing root rot of European oaks. Mycol. Res. 1999, 103, 785–798. [Google Scholar] [CrossRef]
- Thines, M. Bridging the Gulf: Phytophthora and downy mildews are connected by rare grass parasites. PLoS ONE 2009, 4, e4790. [Google Scholar] [CrossRef] [PubMed]
- Barreto, R.W.; Dick, M.W. Monograph of Basidiophora (Oomycetes) with the description of a new species. Bot. J. Linn. Soc. 1991, 107, 313–332. [Google Scholar] [CrossRef]
- Telle, S.; Thines, M. Reclassification of an enigmatic downy mildew species on lovegrass (Eragrostis) to the new genus Eraphthora, with a key to the genera of the Peronosporaceae. Mycol. Prog. 2012, 11, 121–129. [Google Scholar] [CrossRef]
- Thines, M.; Telle, S.; Choi, Y.-J.; Tan, Y.P.; Shivas, R.G. Baobabopsis, a new genus of graminicolous downy mildews from tropical Australia, with an updated key to the genera of downy mildews. IMA Fungus 2015, 6, 483–491. [Google Scholar] [CrossRef]
- Crouch, J.A.; Davis, W.J.; Shishkoff, N.; Castroagudín, V.L.; Martin, F.; Michelmore, R.; Thines, M. Peronosporaceae species causing downy mildew diseases of Poaceae, including nomenclature revisions and diagnostic resources. FUSE 2022, 9, 43–86. [Google Scholar] [CrossRef]
- Baxter, L.; Tripathy, S.; Ishaque, L.; Boot, N.; Cabral, A.; Kemen, E.; Thines, M.; Ah-Fong, A.; Anderson, R.; Badejoko, W.; et al. Signatures of adaptation to obligate biotrophy in the Hyaloperonospora arabidopsis genome. Science 2010, 330, 1549–1551. [Google Scholar] [CrossRef]
- Falloon, R.E.; Sutherland, P.W. Peronospora viciae on Pisum sativum: Morphology of asexual and sexual reproductive structures. Mycologia 1996, 88, 473–483. [Google Scholar] [CrossRef]
- Nordskog, B.; Gadoury, D.M.; Seem, R.C.; Hermansen, A. Impact of diurnal periodicity, temperature, and light on sporulation of Bremia lactucae. Phytopathology 2007, 97, 979–986. [Google Scholar] [CrossRef]
- Kandel, S.L.; Mou, B.; Shishkoff, N.; Shi, A.; Subbarao, K.V.; Klosterman, S.J. Spinach downy mildew: Advances in our understanding of the disease cycle and prospects for disease management. Plant Dis. 2019, 103, 791–803. [Google Scholar] [CrossRef]
- Brown, A.V.; Brasier, C.M. Colonization of tree xylem by Phytophthora ramorum, P. kernoviae and other Phytophthora species. Plant Pathol. 2007, 56, 227–241. [Google Scholar] [CrossRef]
- Dick, M.A.; Williams, N.M.; Bader, M.K.-F.; Gardner, J.F.; Bulman, L.S. Pathogenicity of Phytophthora pluvialis to Pinus radiata and its relation with red needle cast disease in New Zealand. N. Z. J. For. Sci. 2014, 44, 6. [Google Scholar] [CrossRef]
- Scanu, B.; Linaldeddu, B.T.; Peréz–Sierra, A.; Deidda, A.; Franceschini, A. Phytophthora ilicis as a leaf and stem pathogen of Ilex aquifolium in Mediterranean islands. Phytopathol. Mediterr. 2014, 53, 480–490. [Google Scholar]
- Sanfuentes, E.; Fajardo, S.; Sabag, M.; Hansen, E.; González, M. Phytophthora kernoviae isolated from fallen leaves of Drymis winteri in native forest of southern Chile. Australas. Plant Dis. Notes 2016, 11, 19. [Google Scholar] [CrossRef]
- Jung, T.; Horta Jung, M.; Webber, J.F.; Kageyama, K.; Hieno, A.; Masuya, H.; Uematsu, S.; Pérez-Sierra, A.; Harris, A.R.; Forster, J.; et al. The destructive tree pathogen Phytophthora ramorum originates from the Laurosilva forests of East Asia. J. Fungi 2021, 7, 226. [Google Scholar] [CrossRef]
- Brasier, C.M.; Griffin, M.J. Taxonomy of Phytophthora palmivora on cocoa. Trans. Br. Mycol. Soc. 1979, 71, 111–143. [Google Scholar] [CrossRef]
- Rajalakshmy, V.K.; Joseph, A.; Arthassery, S. Occurrence of two mating groups in Phytophthora meadii causing abnormal leaf fall disease of rubber in South India. Trans. Br. Mycol. Soc. 1985, 85, 723–725. [Google Scholar] [CrossRef]
- Drenth, A.; Guest, D.I. Diversity and Management of Phytophthora in Southeast Asia; Australian Centre for International Agricultural Research: Canberra, Australia, 2004. [Google Scholar]
- Cerqueira, A.O.; Luz, E.D.M.N.; De Souza, J.T. First record of Phytophthora tropicalis causing leaf blight and fruit rot on breadfruit in Brazil. Plant Pathol. 2006, 55, 296. [Google Scholar] [CrossRef]
- Guest, D.I. Black pod: Diverse pathogens with a global impact on cocoa yield. Phytopathology 2007, 97, 1650–1653. [Google Scholar] [CrossRef]
- Akrofi, A.Y.; Amoako-Atta, I.; Assuah, M.; Asare, E.K. Black pod disease on cacao (Theobroma cacao, L) in Ghana: Spread of Phytophthora megakarya and role of economic plants in the disease epidemiology. Crop Prot. 2015, 72, 66–75. [Google Scholar] [CrossRef]
- Tri, M.V.; Van Hoa, N.; Minh Chau, N.; Pane, A.; Faedda, R.; De Patrizio, A.; Schena, L.; Olsson, C.H.B.; Wright, S.A.I.; Ramstedt, M.; et al. Decline of jackfruit (Artocarpus heterophyllus) incited by Phytophthora palmivora in Vietnam. Phytopathol. Mediterr. 2015, 54, 275–280. [Google Scholar]
- Puglisi, I.; De Patrizio, A.; Schena, L.; Jung, T.; Evoli, M.; Pane, A.; Hoa, N.V.; Tri, M.V.; Wright, S.; Ramstedt, M.; et al. Two previously unknown Phytophthora species associated with brown rot of Pomelo (Citrus grandis) fruits in Vietnam. PLoS ONE 2017, 12, e0172085. [Google Scholar] [CrossRef] [PubMed]
- Chávez-Ramírez, B.; Rodríguez-Velázquez, N.D.; Chávez-Sánchez, M.E.; Vásquez-Murrieta, M.S.; Hernández-Gallegos, M.A.; Velázquez-Martínez, J.R.; Avendaño-Arrazate, C.H.; Estrada-de los Santos, P. Morphological and molecular identification of Phytophthora tropicalis causing black pod rot in Mexico. Can. J. Plant Pathol. 2021, 43, 670–679. [Google Scholar] [CrossRef]
- Patil, B.; Hedge, V.; Sridhara, S.; Pandian, R.T.P.; Thube, S.H.; Palliath, G.K.; Gangurde, S.S.; Jha, P.K. Multigene phylogeny and haplotype analysis reveals predominance of oomycetous fungus, Phytophthora meadii (McRae) associated with fruit rot disease of arecanut in India. Saudi J. Biol. Sci. 2019, 29, 103341. [Google Scholar] [CrossRef]
Disclaimer/Publisher’s Note: The statements, opinions and data contained in all publications are solely those of the individual author(s) and contributor(s) and not of MDPI and/or the editor(s). MDPI and/or the editor(s) disclaim responsibility for any injury to people or property resulting from any ideas, methods, instructions or products referred to in the content. |
© 2023 by the authors. Licensee MDPI, Basel, Switzerland. This article is an open access article distributed under the terms and conditions of the Creative Commons Attribution (CC BY) license (https://creativecommons.org/licenses/by/4.0/).